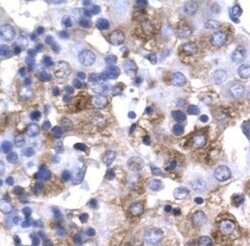
PIT1 Polyclonal Antibody, Invitrogen 50 &mu;g | Buy Online | Invitrogen | Fisher Scientific

Learn More
PIT1 Polyclonal Antibody, Invitrogen™
Descripción
PA1-24436 detects PIT1/POU1F1 in human, mouse, rat, and canine samples. PA1-24436 has been successfully used in Western blot and immunohistochemistry (paraffin) procedures. The PA1-24436 immunogen is a synthetic peptide region of human POU1F1. Store product as a concentrated solution. Centrifuge briefly prior to opening the vial. For short-term storage (1-2 weeks), product can be stored at 4°C. For long-term storage, aliquot and store product at -20° C or below, avioiding multiple freeze-thaw cycles.

Especificaciones
Especificaciones
| Antígeno | PIT1 |
| Aplicaciones | Immunohistochemistry (Paraffin), Western Blot |
| Clasificación | Polyclonal |
| Concentración | 0.5 mg/mL |
| Conjugado | Unconjugated |
| génica | POU1F1 |
| N.º de referencia del gen | Q9TTI7, P28069, Q00286, P10037 |
| Alias de gen | POU1F1 |
| Símbolos de los genes | POU1F1 |
| Especie del huésped | Rabbit |
| Mostrar más |
Al hacer clic en Enviar, acepta que Fisher Scientific se ponga en contacto con usted en relación con los comentarios que ha proporcionado en este formulario. No compartiremos su información para ningún otro fin. Toda la información de contacto proporcionada se mantendrá de acuerdo con nuestra Política de Privacidad. Política de privacidad.